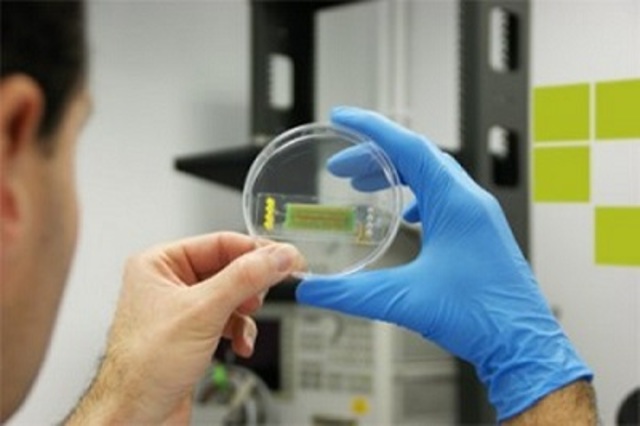
Primera Compañía especializada Ingeniería

-
Se tienen registros de momias con prótesis (p.ej. Falanges)
-
-
Robert Hooke descubre la célula
-
Inocula virus de viruela
-
-
El personal médico y los investigadores en el campo de la biología se valían de técnicas de ingeniería clásica (mecánica y carpintería por ejemplo)
-
Biólogos adquirieron sólidos fundamentos en el campo de la electrónica, dando paso a la aplicación de técnicas más elaboradas en la resolución de los problemas biológicos y médicos.
-
Invención del primer estetoscopio
-
-
Desarrolló vacunas, los antibióticos, la esterilización y la higiene como métodos efectivos de cura y prevención contra la propagación de las enfermedades infecciosas.
-
Utiliza los rayos X con fines diagnosticos
-
Acondicionamiento de espacios quirúrgicos adecuados
-
Descubrió las capacidades antibióticas de la penicilina
-
-
Primera colaboración de ingenieros para la confección de materiales médicos
-
Biólogos estaban familiarizados a los últimos adelantos en el campo de la electrónica dejando atrás el manejo de válvulas y grandes componentes, para dar lugar a transistores y componentes en miniatura.
-
Rosalind Franklin, James Watson y Francis Crick describen la estructura de la doble hélice en el ADN
-
Se construye una máquina (corazón-pulmón) para ayudar en cirugía de corazón abierto
-
Se utiliza por primera vez el término Bioingeniería
-
-
-
-
-
-
-
La tecnología de los materiales y de las estructuras en la que el orden de magnitud se mide en nanómetros, con aplicación a la física, la química y la biología
-
Se descifró la secuencia completa (99,99%)
-
El doctor Yuval Ebenstein y la doctora Yael Michaelo, del Departamento de Física Química de la Universidad de Tel Aviv, aseguran que es el combustible a base de algas la mejor forma de producir energía
-
-
-
-
-
Looking for a timeline maker?
Create timelines for projects, roadmaps, history, lessons, legal cases, and stories with Timetoast. Timetoast is a timeline maker for work, school, research, and stories.